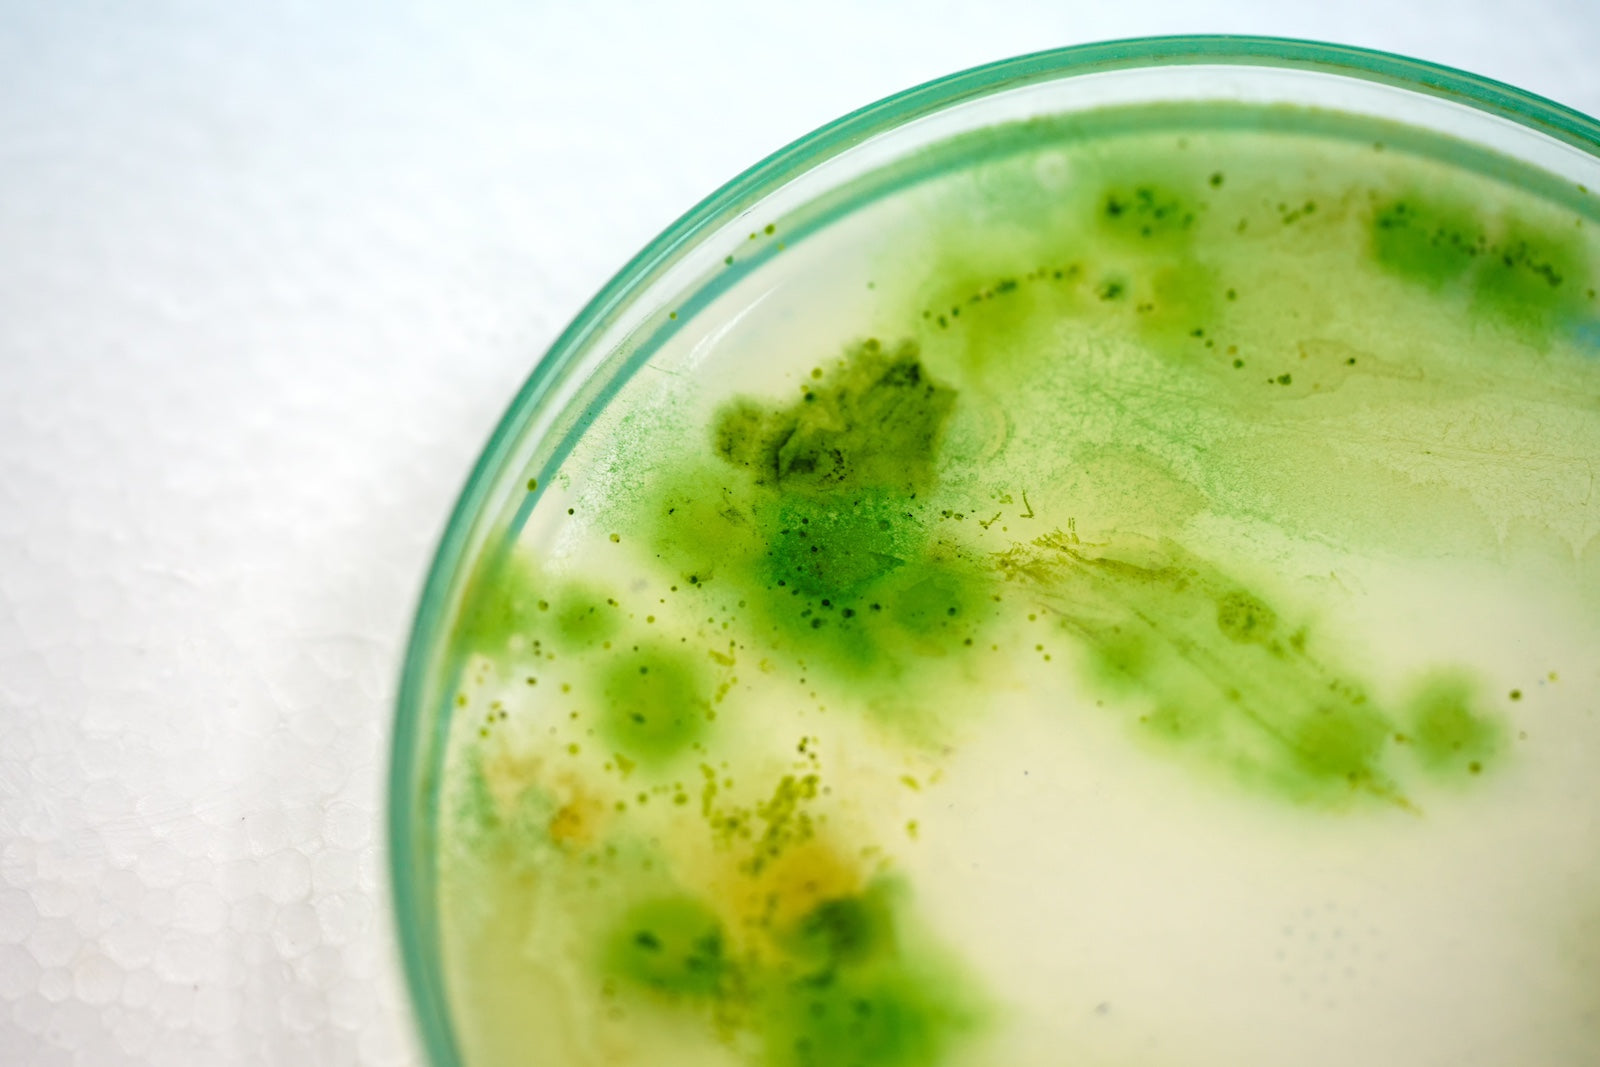
green chemicals in petri dish

Who we are
Flora Materials is a biomaterials company committed to building a more sustainable future — for our planet and for the building industry.

Our product designers, scientists, and engineers are working together to achieve the most functional, sustainable, and well designed building materials using bio-based alternatives.

Studying popular building materials, we’re working to replace toxic chemicals like petroleum polymers with bio-based alternatives like algae — without compromising performance.

As a team, we bring together the talents of architects and designers, engineers and scientists to produce exceptionally designed materials.

Our in-house lab tests performance standards prior to product testing and deployment. Then we use a network of contractors, homeowners, interior designers, architects, and developers for material testing and analysis during product development. Finally, we’re accelerating the adoption of bio-based materials by putting our products to the test at West 40 Studio, tracking installation and performance on our real construction/design projects.

By sourcing materials entirely in the U.S., we’re shrinking our environmental footprint — resulting in cost savings, reduced waste through product recycling, and lower environmental impact from project shipping.
Our product designers, scientists, and engineers are working together to achieve the most functional, sustainable, and well designed building materials using bio-based alternatives.
Studying popular building materials, we’re working to replace toxic chemicals like petroleum polymers with bio-based alternatives like algae — without compromising performance.
As a team, we bring together the talents of architects and designers, engineers and scientists to produce exceptionally designed materials.
Our in-house lab tests performance standards prior to product testing and deployment. Then we use a network of contractors, homeowners, interior designers, architects, and developers for material testing and analysis during product development. Finally, we’re accelerating the adoption of bio-based materials by putting our products to the test at West 40 Studio, tracking installation and performance on our real construction/design projects.
By sourcing materials entirely in the U.S., we’re shrinking our environmental footprint — resulting in cost savings, reduced waste through product recycling, and lower environmental impact from project shipping.

Our Affiliates
